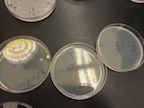
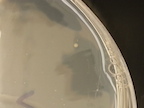

Uploads by Hannah T Sherman
From OpenWetWare
Jump to navigationJump to search
This special page shows all uploaded files.
| Date | Name | Thumbnail | Size | Description |
|---|---|---|---|---|
| 20:02, 22 March 2014 | Screen Shot 2014-03-22 at 4.01.09 PM.png (file) | 72 KB | ||
| 20:00, 22 March 2014 | Screen Shot 2014-03-22 at 3.53.47 PM.png (file) | 78 KB | ||
| 20:00, 22 March 2014 | Screen Shot 2014-03-22 at 3.51.41 PM.png (file) | 72 KB | ||
| 01:49, 17 March 2014 | Screen Shot 2014-03-16 at 9.47.11 PM.png (file) | 56 KB | ||
| 02:40, 1 March 2014 | Bugs hs.png (file) | 52 KB | ||
| 22:41, 28 February 2014 | Hs Lab1 1.png (file) | 86 KB | ||
| 18:03, 26 February 2014 | Lab1 8.png (file) | 38 KB | ||
| 18:03, 26 February 2014 | Lab1 7.png (file) | 101 KB | ||
| 18:03, 26 February 2014 | Lab1 5.png (file) | 33 KB | ||
| 18:03, 26 February 2014 | Lab1 4.png (file) | 86 KB | ||
| 18:03, 26 February 2014 | Lab1 1.png (file) | 41 KB | ||
| 17:52, 26 February 2014 | Lab1 6.png (file) | 203 KB | ||
| 17:51, 26 February 2014 | Lab1 3.png (file) | 41 KB | ||
| 17:51, 26 February 2014 | Image 5 lab 3.jpg (file) | ![]() |
21 KB | |
| 19:45, 22 February 2014 | Image 7 lab 3.jpg (file) | ![]() |
17 KB | |
| 19:45, 22 February 2014 | Image 6 lab 3.jpeg (file) | ![]() |
18 KB | |
| 19:45, 22 February 2014 | Image 4 lab 3.jpg (file) | ![]() |
18 KB | |
| 19:35, 22 February 2014 | Image 3 lab 3.jpg (file) | ![]() |
14 KB | |
| 19:35, 22 February 2014 | Image 2 lab 3.jpg (file) | ![]() |
15 KB | |
| 19:22, 19 February 2014 | 20140115 155420.jpg (file) | 263 KB | ||
| 05:57, 10 February 2014 | AP edits Bio lab 2 210 draft 2.docx (file) | 174 KB | ||
| 05:52, 10 February 2014 | AP edits Lad final draft write up for lab 1 Biological life at au (1).docx (file) | 198 KB | ||
| 05:47, 10 February 2014 | Bio 210 lab 1.jpg (file) | 53 KB | ||
| 17:27, 31 January 2014 | Lad Draft 2 write up for lab 1 Biological life at au.docx (file) | 115 KB | January 31,2014 State the question / problem / objective: This lab was set up to help use understand natural selection and the characteristics of a niche in biotic and abiotic. This lab addresses these objectives through by observing and taking notes on |